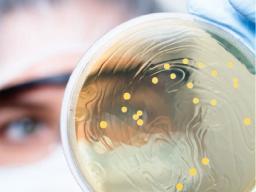
Microbiology - ZeptoMetrix - Analytical Reference Materials - Environmental

Microbiology
We offer ISO-accredited microbiological certified reference materials. Validated and traceable cultures are no more than two passages from the primary reference culture ensuring genetic traceability to the primary cell line. Each lyophilized culture is preserved in our proprietary Microgel-Flash™ quick dissolve matrix. Pellets dissolve instantly once hydrated. Manufactured and tested under ISO 17034 and 17025 accreditations.

The supplier does not provide quotations for this product through SelectScience. You can search for similar products in our Product Directory.
We offer the broadest selection of microbiological certified reference materials so you can ensure the accuracy of your results.
What really matters to you:
- Easy-to-use Traceable - never more than two passages from the primary culture 24 month shelf life for most products
- Quality assured - ISO 17025 and ISO 17034 accredited
Featured Products:
Unit Dose™ Microbiological Controls Quantitative Cultures for USP 51, 61, and 62 Snap Stick™ Ready-to-Use Culture Swabs
Emerging contaminants for food and packaging
Wednesday, June 25, 2025 at 16:00 BST / 17:00 CEST / 11:00 EDT / 08:00 PDT
As concerns grow around the presence of harmful substances in our food and its packaging, laboratories play a crucial role in identifying and monitoring potential threats to public health. Join us for this expert webinar and explore the latest emerging contaminants in food and packaging, as well as the advanced analytical techniques used to detect them.
This webinar will cover key microbiological pathogens, organic and inorganic chemical residues, and packaging-derived toxins that are gaining attention as potential human health risks. Learn how to strengthen your food safety testing strategy by staying ahead of regulatory requirements and identifying high-risk analytical targets across the food production and packaging lifecycle.
Key learning objectives
Identify analytical targets for food safety, including microbiological pathogens, organic and inorganic chemicals, and packaging toxins.
Who should attend?
Analytical scientists interested in food and food packaging analysis.
Certificate of attendance
If you attend the live webinar, you will automatically receive a certificate of attendance, including a learning outcomes summary, for continuing education purposes.
If you view the on-demand webinar, you can request a certificate of attendance by emailing editor@selectscience.net.